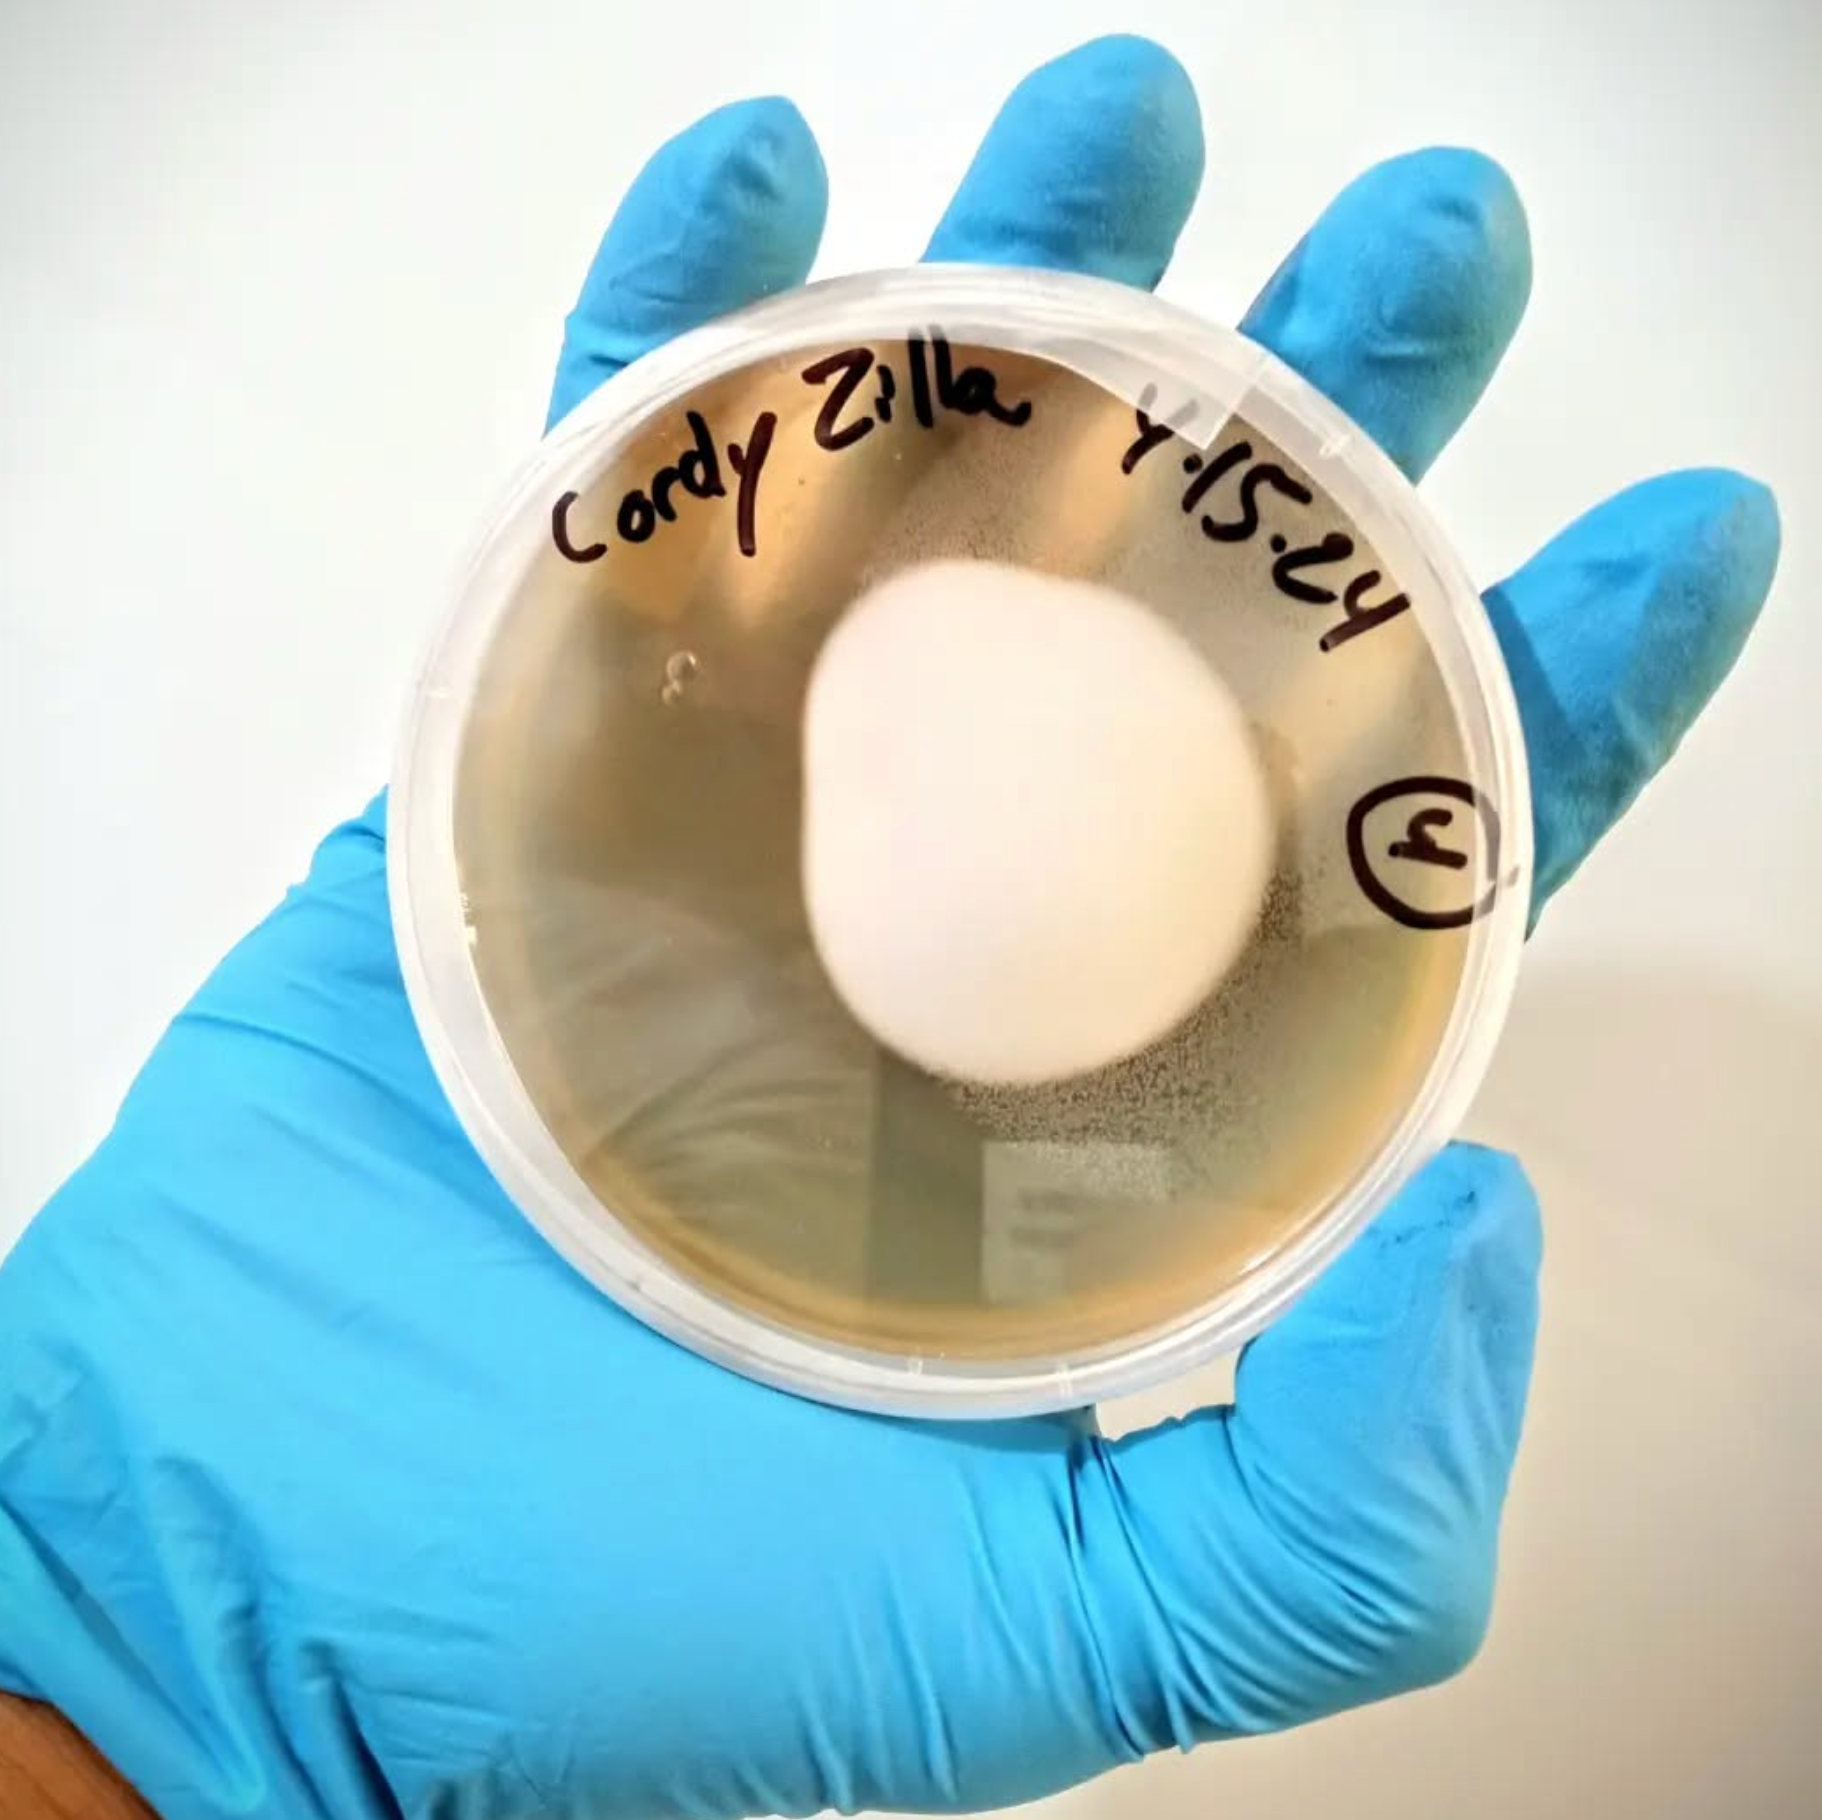

Resting Point Farms Mushroom Store
Retainer for Landscaping Services and Custom Projects
Retainer for Landscaping Services and Custom Projects
Couldn't load pickup availability
Our retainer fee is an advance payment made to our farm professionals to secure future services and reserve time on our schedule. The primary purpose is to guarantee our professional's availability for the client's specific needs and to cover initial research, travel, and supplies. Upon payment received, you will be contacted within 3-5 business days to form a service and/or project plan. This includes goals, parameters, timeline, budget, etc. The following services and projects are available:
- Mushroom Farm Consult - Start your own mushroom farm! Includes 2 hour private educational session, follow-up sessions, 5 illustrated cultivation infographics and recipes, + option of logs made to order customized for your business plan, + option for regional delivery
- Poison Ivy Removal - Environmentally Friendly - Toxicodendron radicans
- Mushroom Garden Bed Installation - Winecap Mushroom Stropharia rugosoannulata
- Mushroom Log Installation - Shiitake Mushroom, Lion's Mane, Oyster, Maitake, Stropharia rugosoannulata
- Flower Bed Installation - Butterfly Milkweed Asclepias tuberosa, Purple Coneflower Echinacea purpurea, etc.
- Hydroponic Installation - Indoor herbs and greens, Lactuca ssp., Spinacia ssp., etc.
-
Microgreens Installation - Indoor sunflower greens Helianthus ssp., sweet pea shoots Lathyrus ssp., wheatgrass Agropyron, basils Ocimum ssp., etc.
-
Young Tree Removal - Poplar Liriodendron tulipifera, Oak Quercus, Hickory Carya etc. under 5 years old.
Please note: in-person service is limited to the following counties in North Carolina, US: Buncombe County, Haywood County, Henderson County, Madison County, McDowell County, Transylvania County, Yancey County.
Our supplies are sourced locally and regionally. Some of our suppliers include: Flying Cloud Farm, Eden Brothers, Fifth Season Gardening Co., Reems Creek Nursery.